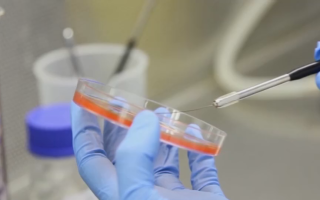

Exclusive: Bank scammers impersonate Prime Minister Anthony Albanese
We now live in the age of digital subterfuge. At AMP Headquarters, the anti-fraud team has been testing new technology to identify...

Meet London’s viral pickpocket hunter
On a usual day, Diego Galdino delivers food across London on his trusty e-bike. But in his spare time, the Brazilian expat...

Sacked Qantas workers vindicated
He’s one of the faces of the biggest corporate crime in Australian history. Don Dixon worked as a baggage handler at Qantas...

The mothers who say they’ll never take their children back to daycare
Are our kids safe in daycare? Two mothers have spoken to 10 News+ about why they say they’ll never go back to...

Explained: Why Aussie public schools are losing students to private education
For the Poudel family, education is a priority. So, when it came time for Anwesh to head to high school, his parents...

Mum’s warning to parents about devastating effects of common virus
CMV, or Cytomegalovirus, is a viral herpes infection that 85 per cent of people will acquire by the age of 40. Many...

Greens candidate Hannah Thomas speaks out after police clash
Former Greens candidate Hannah Thomas sits down with 10 News+ for her first TV interview since her eye injury from a clash...
Fierce debate rages over ethics of IVF gender selection
Should parents be allowed to choose the sex of their children? For Australian families, that choice is banned. However, in countries with...

Why the US is weighing in on how Australia deals with kangaroos
Every night kangaroos decimate the crops of hard-working Australian farmers, leaving them in a very difficult position. Now is America wants a...